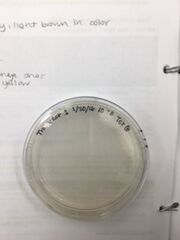
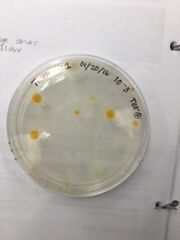

Uploads by Alyssa Lillian
From OpenWetWare
Jump to navigationJump to search
This special page shows all uploaded files.
| Date | Name | Thumbnail | Size | Description |
|---|---|---|---|---|
| 02:49, 31 March 2016 | AlyssaLillian foodweb.jpg (file) |  |
13 KB | |
| 02:01, 30 March 2016 | AlyssaLillian ZF scoring chart.png (file) |  |
33 KB | |
| 02:01, 30 March 2016 | AlyssaLillian ZF rating graph.png (file) |  |
28 KB | |
| 02:01, 30 March 2016 | AlyssaLillian ZF developmental stages.png (file) |  |
201 KB | |
| 01:53, 30 March 2016 | AlyssaLillian swim bladder abnormalities.png (file) |  |
111 KB | |
| 01:53, 30 March 2016 | AlyssaLillian shape abnormalities.png (file) |  |
195 KB | |
| 01:53, 30 March 2016 | AlyssaLillian pigmentation abnormalities.png (file) |  |
109 KB | |
| 01:53, 30 March 2016 | AlyssaLillian fin abnormalities.png (file) |  |
190 KB | |
| 01:53, 30 March 2016 | AlyssaLillian eye abnormalities.png (file) |  |
162 KB | |
| 06:11, 2 March 2016 | AlyssaLillian gel2.JPG (file) |  |
632 KB | |
| 06:11, 2 March 2016 | AlyssaLillian gel1.JPG (file) |  |
612 KB | |
| 07:45, 24 February 2016 | AlyssaLillian louse.JPG (file) |  |
20 KB | |
| 07:45, 24 February 2016 | AlyssaLillian inv top.JPG (file) |  |
20 KB | |
| 07:45, 24 February 2016 | AlyssaLillian inv bottom.jpg (file) |  |
35 KB | |
| 07:45, 24 February 2016 | AlyssaLillian beetle.JPG (file) |  |
19 KB | |
| 07:12, 17 February 2016 | AlyssaLillian Plant5CS.JPG (file) |  |
21 KB | |
| 07:12, 17 February 2016 | AlyssaLillian Plant5.JPG (file) |  |
24 KB | |
| 07:12, 17 February 2016 | AlyssaLillian Plant4CS.JPG (file) |  |
20 KB | |
| 07:12, 17 February 2016 | AlyssaLillian Plant4.JPG (file) |  |
25 KB | |
| 07:12, 17 February 2016 | AlyssaLillian Plant3.JPG (file) |  |
25 KB | |
| 07:11, 17 February 2016 | AlyssaLillian Plant2CS.JPG (file) |  |
22 KB | |
| 07:11, 17 February 2016 | AlyssaLillian Plant2 Leaves.JPG (file) |  |
31 KB | |
| 07:11, 17 February 2016 | AlyssaLillian Plant2.JPG (file) |  |
31 KB | |
| 07:11, 17 February 2016 | AlyssaLillian Plant1CS.JPG (file) |  |
26 KB | |
| 07:11, 17 February 2016 | AlyssaLillian Plant1.JPG (file) |  |
30 KB | |
| 04:01, 12 February 2016 | AlyssaLillian grampos.JPG (file) |  |
22 KB | |
| 04:01, 12 February 2016 | AlyssaLillian gramneg.JPG (file) |  |
23 KB | |
| 12:22, 10 February 2016 | AlyssaLillian table1.png (file) | 30 KB | ||
| 12:16, 10 February 2016 | AlyssaLillian table1.xlsx (file) | 37 KB | ||
| 11:54, 10 February 2016 | AlyssaLillian Tet-9 Plate.JPG (file) |  |
19 KB | |
| 11:54, 10 February 2016 | AlyssaLillian Tet-7 Plate.JPG (file) |  |
18 KB | |
| 11:54, 10 February 2016 | AlyssaLillian Tet-7 Cells.JPG (file) |  |
18 KB | |
| 11:54, 10 February 2016 | AlyssaLillian Tet-3 Cells.JPG (file) |  |
23 KB | |
| 11:54, 10 February 2016 | AlyssaLillian Tet-5 Plate.JPG (file) | |
20 KB | |
| 11:53, 10 February 2016 | AlyssaLillian Tet-3 Plate.JPG (file) | |
19 KB | |
| 11:53, 10 February 2016 | AlyssaLillian Normal-9 Plate.JPG (file) |  |
23 KB | |
| 11:53, 10 February 2016 | AlyssaLillian Normal-7 Plate.JPG (file) |  |
22 KB | |
| 11:53, 10 February 2016 | AlyssaLillian Normal-5 Plate.JPG (file) |  |
23 KB | |
| 11:53, 10 February 2016 | AlyssaLillian Normal-3 Plate.JPG (file) |  |
19 KB | |
| 00:38, 3 February 2016 | AlyssaLillian serial dilution diagram.JPG (file) |  |
26 KB | |
| 18:48, 27 January 2016 | Transect tree.JPG (file) |  |
1.02 MB | |
| 18:48, 27 January 2016 | Transect plant ID.JPG (file) |  |
592 KB | |
| 18:48, 27 January 2016 | Transect aerial view.JPG (file) |  |
417 KB | |
| 18:48, 27 January 2016 | Peranema top.JPG (file) |  |
205 KB | |
| 18:48, 27 January 2016 | AlyssaLillian transect.JPG (file) |  |
1.06 MB | |
| 18:48, 27 January 2016 | Oedogonium top.JPG (file) |  |
457 KB | |
| 18:48, 27 January 2016 | Colpidium middle.JPG (file) |  |
90 KB | |
| 18:48, 27 January 2016 | AlyssaLillian hay infusion.JPG (file) |  |
456 KB | |
| 18:48, 27 January 2016 | AlyssaLillian hay infusion bottom.JPG (file) |  |
347 KB | |
| 18:48, 27 January 2016 | Alyssa Lillian hay infusion top.JPG (file) |  |
592 KB |